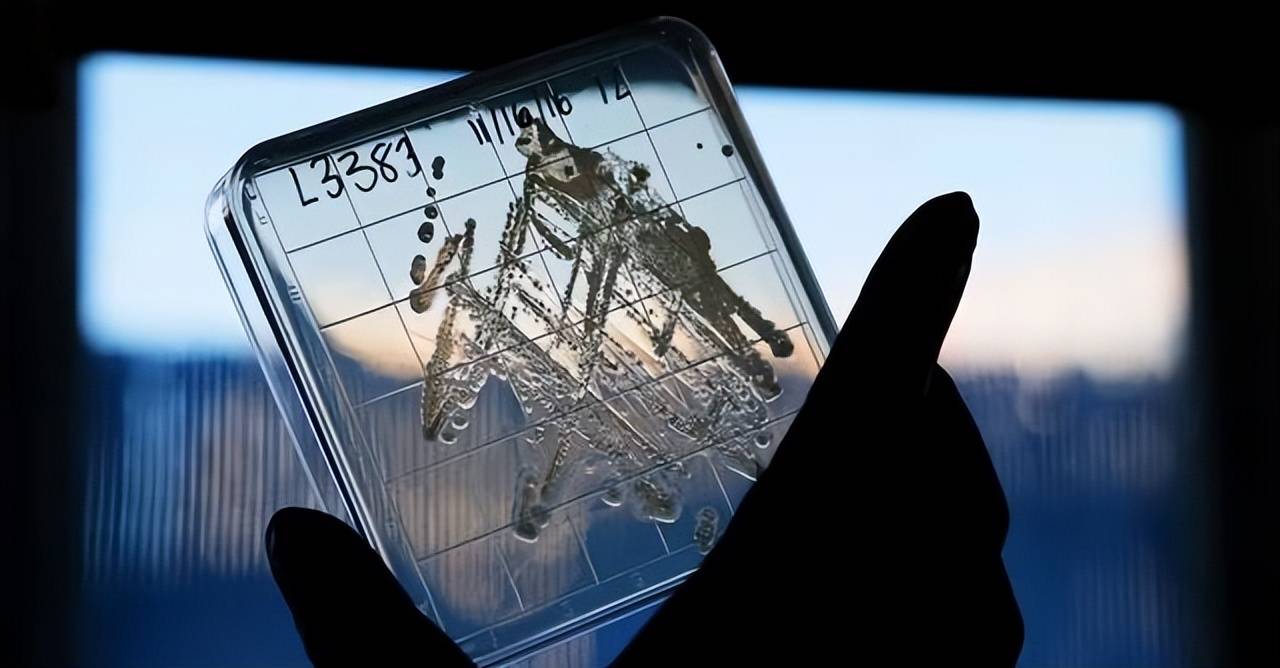

在上世纪五六十年代,日本的制药业曾经处于全球领先地位,工厂主要集中在东京、大阪等地,生产抗生素和药品原料,供应国内外市场。欧美国家也在其中扮演着重要角色,全球市场稳定且分工明确。然而,随着九十年代全球化的加速,劳动力成本上升、环保标准日益严格,日本的药品生产逐渐遇到了瓶颈。企业的董事会看到成本报表后,决定逐步关闭本土的生产线,将生产转移到海外,特别是中国。中国不仅有坚实的化工基础,而且政策支持力度大,这使得日企纷纷将生产线建设到中国,由日本工程师带着技术图纸,帮助建厂并教导工人如何操作设备。

中国借此机会扩大了生产规模,生产线越来越多,产量迅速增长,到本世纪初,中国已经成为全球大宗原料药的主要供应国。与此同时,许多日本药厂为了获得更多利润,主动减少了本土的生产能力。比如,青霉素、链霉素等生产线闲置,工人换岗,最终转而从中国进口原料。β-内酰胺类抗生素原料的依赖度甚至几乎达到了百分之百。这种变化虽然出于经济利益的考虑,却忽视了长远的风险。

近年来,日本右翼推动军事扩张,中国则通过管控两用物项的出口来回应。在这种背景下,日本的企业发现自己的库存日益紧张,采购员不断催货,生产线因缺料而停摆,工人只能等待。而相较于稀土的紧张,抗生素和药品原料的供应问题更为严重,直接关系到日本民生。日本的医院在手术时所需的药品原料,大多数都来自进口。一旦这些供应中断,后果将不堪设想。

日本的制药行业,尤其是抗生素的生产,早在九十年代就开始逐渐转移到中国。中国不仅凭借低廉的生产成本占领了全球市场,还通过政府的支持和完善的化工基础设施,迅速成长为全球药品原料的供应大国。日本对于抗生素的依赖几乎是百分之百,尤其是在β-内酰胺类原料药方面,几乎所有供应都来自中国。

2019年前后,随着日本本土药品生产的利润下降,药企纷纷缩减了青霉素、链霉素等本土产能,转而依赖中国的进口。中国在抗生素领域的领先地位,类似于稀土领域的格局,是发达国家放弃的市场份额。如今,中国成为这些药品关键原料的最大供应国,尤其是在抗生素领域,依赖中国的比例极高。2019年中国加强了环保措施,关闭了部分相关的药品生产厂,导致日本的抗生素短缺,甚至出现了手术延期的情况。尽管日本政府已经意识到这一结构性风险,并开始尝试脱离对中国的依赖,但由于中国产品成本较低,且复产竞争激烈,日本的药企很难恢复本土生产。

为了应对这一局面,日本政府在2024年拨款550亿日元,支持明治控股和盐野义制药等公司重建抗生素原料设施。尽管企业工程师已经开始测量场地,工人也在安装管道和反应釜,但全球的药品原料供应格局已经发生了变化。中国不仅在抗生素领域占据主导地位,其在全球药品供应链中的重要性也日益突出。
根据全球媒体的行业分析,中国目前已经是近700种关键药物中,至少一种原料的唯一供应国。美国、欧洲等地区的药品生产,也在依赖中国的原料。中国不仅在抗生素等常见药物的原料供应上占据主导地位,其产业规模和成本优势也使得全球供应链的分工愈发深刻。这种分工带来了成本优势,但也使得各国在地缘政治变动时变得脆弱。

欧美国家在创新药物研发方面具有优势,但在药品原料供应方面,他们却在全球化过程中越来越依赖中国。中国的反制措施虽然主要集中在军事领域,但也对日本等国家的药品供应造成了压力。日本的企业已经开始急于增加库存,以防中国的反制措施进一步升级。2020年,日本感染症学会理事长馆田一博在接受采访时表示,尽管他知道中国已经限制了稀土出口,但他希望中国的政策不要扩展到药品领域。然而,随着局势的发展,特别是日本右翼的扩张政策,中国可能会进一步采取更强有力的措施来保障地区稳定和全球和平。

目前,中国尚未将反制措施扩展到药品原料领域,这为日本提供了调整的空间。但如果日本继续推动右翼势力扩张,中国可能会采取更加严格的措施,确保亚洲和全球的和平稳定。企业采购员已开始监控市场,调节订单,而日本的医院也正在恢复手术,药品生产线的产量慢慢恢复。然而,尽管日本政府努力推进多元化供应,投资海外矿产,但进展仍然有限。与此同时,中国的药品原料供应依旧稳定,港口集装箱堆积如山,轮船不断出发,全球供应链正在调整,各国在寻求平衡,但中国的地位依然稳固。